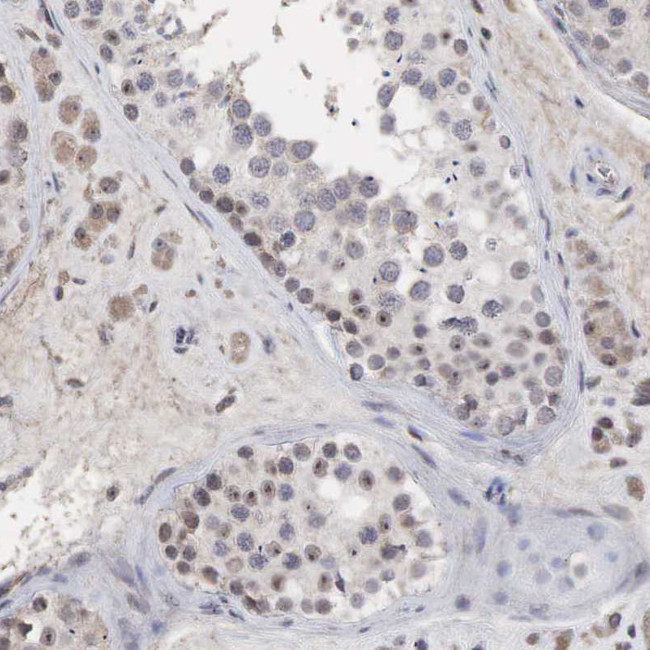
DKC1 Antibody in Immunohistochemistry (Paraffin) (IHC (P))

Search
Invitrogen
DKC1 Polyclonal Antibody
{{$productOrderCtrl.translations['antibody.pdp.commerceCard.promotion.promotions']}}
{{$productOrderCtrl.translations['antibody.pdp.commerceCard.promotion.viewpromo']}}
{{$productOrderCtrl.translations['antibody.pdp.commerceCard.promotion.promocode']}}: {{promo.promoCode}} {{promo.promoTitle}} {{promo.promoDescription}}. {{$productOrderCtrl.translations['antibody.pdp.commerceCard.promotion.learnmore']}}
产品信息
PA5-110612
种属反应
宿主/亚型
分类
类型
抗原
偶联物
形式
浓度
规格
纯化类型
保存液
内含物
保存条件
运输条件
RRID
产品详细信息
Immunogen sequence: EAGTYIRTLC VHLGLLLGVG GQMQELRRVR SGVMSEKDHM VTMHDVLDAQ WLYDNHKDES YLRRVVYPLE KLLTSHKRLV MKDSAVNAIC YGAKIMLPGV LRYEDGIEVN QEIVVIT
Highest antigen sequence indentity to the following orthologs: Mouse - 99%, Rat - 92%.
靶标信息
This gene is a member of the H/ACA snoRNPs gene family. snoRNPs are involved in various aspects of rRNA processing and modification and have been classified into two families: C/D and H/ACA. The H/ACA snoRNPs also include the NOLA1, 2 and 3 proteins. The protein encoded by this gene and the three NOLA proteins localize to the dense fibrillar components of nucleoli and to coiled bodies in the nucleus. Both 18S rRNA production and rRNA pseudouridylation are impaired if any one of the four proteins is depleted. These four H/ACA snoRNP proteins are also components of the telomerase complex. The protein encoded by this gene is related to the Saccharomyces cerevisiae Cbf5p and Drosophila melanogaster Nop60B proteins. The gene lies in a tail-to-tail orientation with the palmitoylated erythrocyte membrane protein gene and is transcribed in a telomere to centromere direction. Both nucleotide substitutions and single trinucleotide repeat polymorphisms have been found in this gene. Mutations in this gene cause X-linked dyskeratosis congenita, a disease resulting in reticulate skin pigmentation, mucosal leukoplakia, nail dystrophy, and progressive bone marrow failure in most cases. Mutations in this gene also cause Hoyeraal-Hreidarsson syndrome, which is a more severe form of dyskeratosis congenita. Two transcript variants encoding different isoforms have been found for this gene.
仅用于科研。不用于诊断过程。未经明确授权不得转售。
篇参考文献 (0)
生物信息学
蛋白别名: CBF5 homolog; dyskeratosis congenita 1, dyskerin; Dyskerin; H/ACA ribonucleoprotein complex subunit 4; H/ACA ribonucleoprotein complex subunit 4 isoform 3; H/ACA ribonucleoprotein complex subunit DKC1; Nopp140-associated protein of 57 kDa; nucleolar protein; Nucleolar protein family A member 4; Nucleolar protein NAP57; snoRNP protein DKC1
基因别名: CBF5; CHINE1; DKC; DKC1; DKCX; NAP57; NOLA4; XAP101
UniProt ID: (Human) O60832
Entrez Gene ID: (Human) 1736